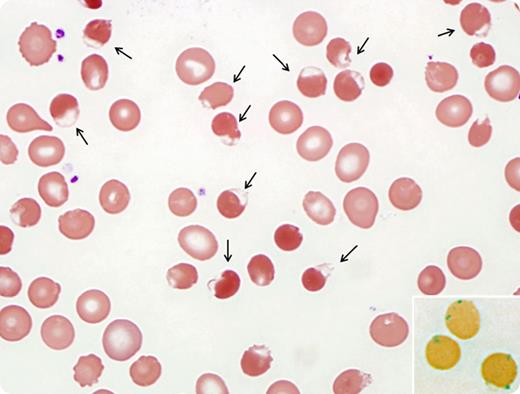

A 58-year-old male with refractory chronic lymphocytic leukemia presented for clinical trial. Prior to treatment, he received rasburicase to prevent tumor lysis syndrome. Within 24 hours, the patient developed an acute hemolysis. The blood smear showed numerous abnormal red blood cells (RBCs) characterized by membranous defects (bite cells) or submembranous blisterlike structures (blister cells). Bite and blister cells are the morphologic hallmark of Heinz body hemolytic anemia (HBHA). Heinz bodies are invisible in a Giemsa-stained smear, but they can be highlighted by supravital staining as 1- to 3-μm inclusions in RBCs (inset). HBHA in this patient is likely secondary to rasburicase, given that he had intermediate glucose-6-phosphate dehydrogenase (G6PD) on screening and resolution of hemolysis after discontinuing rasburicase.
Various oxidant drugs such as dapsone, primaquine, methylene blue, and rasburicase may induce HBHA in individuals susceptible to oxidant stress. Rasburicase is a recombinant urate oxidase that promotes uric acid degradation to a more water-soluble compound; it is contraindicated in patients with G6PD deficiency because of the hemolytic potential of an oxidative byproduct of uric acid breakdown. It is important to recognize the morphologic features of HBHA in blood smears because the bite and blister cells may serve as the initial alert of HBHA.
A 58-year-old male with refractory chronic lymphocytic leukemia presented for clinical trial. Prior to treatment, he received rasburicase to prevent tumor lysis syndrome. Within 24 hours, the patient developed an acute hemolysis. The blood smear showed numerous abnormal red blood cells (RBCs) characterized by membranous defects (bite cells) or submembranous blisterlike structures (blister cells). Bite and blister cells are the morphologic hallmark of Heinz body hemolytic anemia (HBHA). Heinz bodies are invisible in a Giemsa-stained smear, but they can be highlighted by supravital staining as 1- to 3-μm inclusions in RBCs (inset). HBHA in this patient is likely secondary to rasburicase, given that he had intermediate glucose-6-phosphate dehydrogenase (G6PD) on screening and resolution of hemolysis after discontinuing rasburicase.
Various oxidant drugs such as dapsone, primaquine, methylene blue, and rasburicase may induce HBHA in individuals susceptible to oxidant stress. Rasburicase is a recombinant urate oxidase that promotes uric acid degradation to a more water-soluble compound; it is contraindicated in patients with G6PD deficiency because of the hemolytic potential of an oxidative byproduct of uric acid breakdown. It is important to recognize the morphologic features of HBHA in blood smears because the bite and blister cells may serve as the initial alert of HBHA.
For additional images, visit the ASH IMAGE BANK, a reference and teaching tool that is continually updated with new atlas and case study images. For more information visit http://imagebank.hematology.org.